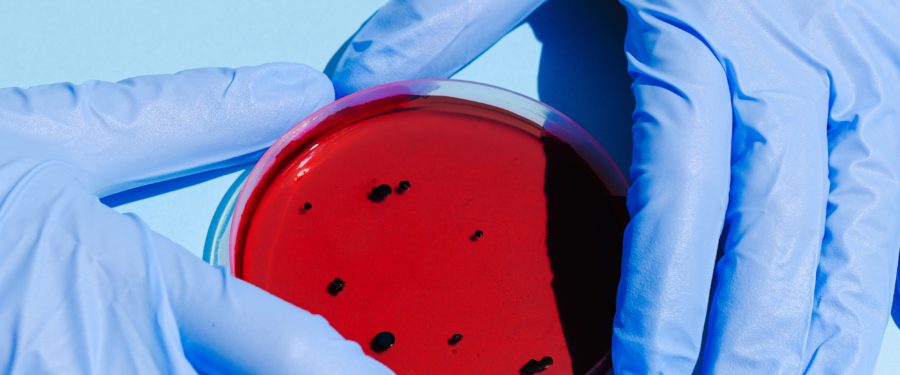
Local Manufacturers Scaling Up Production Of Critical Testing Supplies

STICKY POST
Jasaira Martinez, 13, Missing
The New York City Police Department is seeking the public’s assistance in locating the following female, residing and reported missing from within the confines of the 5th Precinct in Manhattan. Details are as follows. Missing: